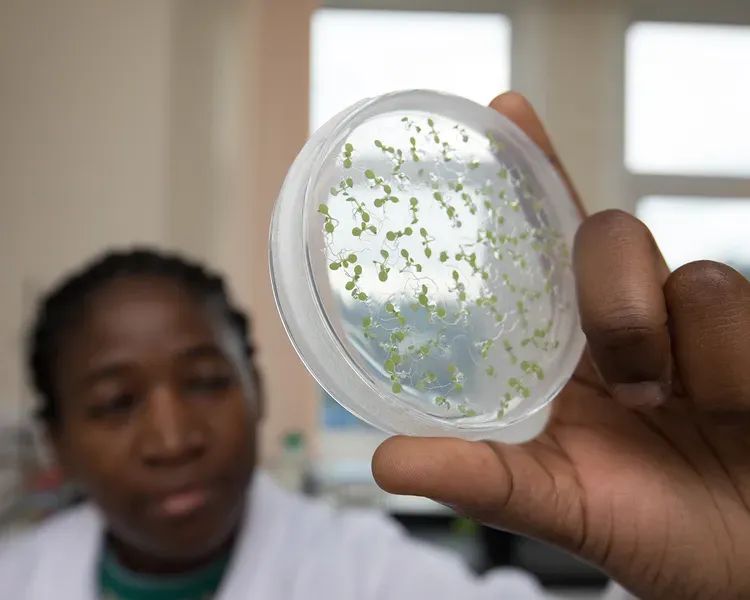

Book now for our Open Days in September and October
Biological Sciences (with a year in industry) BSc (Hons)
Learn about molecules, cells, ecosystems, and whole living organisms. Study biological sciences with an extra placement year working in industry
Start date
September 2026
Duration
5 or 4 years
UCAS Code
C101
Location
Dundee City Campus
Study abroad
Top in the UK for Research Quality in Biological and Biomedical Sciences
Complete University Guide 2027
Biological Sciences is the study of living things. It looks at how they respond to each other and the environment around them.
It studies life in all its forms, focusing on the cellular level. This ranges from molecular and chemical processes to cell function.
Why you should study this biological sciences course
Studying a BSc Biological Sciences degree can prepare you for a wide range of careers. For example, these could be in research, industry, or academia.
You could help solve some of the health or environmental challenges facing our world. This could be working in a research lab, the pharmaceutical industry, or biotechnology. You could also inspire the next generation by going into teaching.
There's also a growing need for people with skills in both science and computing. Bioinformatics combines these two areas to analyse biological data.
Flexibility is at the centre of our life sciences degrees. There is a shared curriculum in the first two years of our undergraduate courses. This lets you try a range of different areas, before focussing on the areas that interest you the most. They include:
- Biological sciences
- Biomedical sciences
- Biochemical sciences
- Plant sciences
- Bioinformatics.
This all helps you develop a wide range of knowledge and skills.
In later years you then choose from a range of modules in specialist areas you want to focus on. You may also be able to change to a different life sciences degree if you choose to.
You have a few options to choose from with this BSc science degree. You can follow the standard route through the course, covering a wider range of topics. Or you can choose to specialise for a named degree in Plant Sciences or Bioinformatics.
This course also allows you to spend a year working in industry. An example of this could be working in a commercial laboratory.
This year-long placement will help you get real-world skills and improve your CV. It also presents you with the opportunity to network and build relationships. This will positively impact your career after graduation.
What you will learn on this course
You start by learning key theories of biology. This takes you from the molecular level right up to full body systems and beyond.
In years one and two you'll explore core areas such as:
- genetics
- cell biology
- biological organisation
- molecular mechanisms and processes.
You'll develop your practical skills, including lab skills, data analysis, and experiment design.
In later years you'll focus on more detailed aspects of biological sciences. You'll have more space to choose modules in areas that interest you, including:
- drug discovery
- immunology
- cancer biology
- data and statistical analysis
- stem cells
- science communication.
The year in industry happens after year three of the main BSc degree. We'll support you to find a suitable placement. However, if a placement is not found, you can transfer to the standard four year BSc course.
Once you return to the final year of your BSc degree, you'll take part in a research project. This could be in one of the areas of world-class research taking place in our School of Life Sciences.
The benefits of studying biological sciences with us
In Life Sciences we do all we can to boost your career opportunities and give you the experience you need. This includes:
- giving you core skills in data analysis and lab safety
- offering a range of lab-based research traineeships or industry internships
- giving you options to study abroad for either a semester or a full year
- opportunities to take an extra year working in industry.
The Royal Society of Biology has accredited this biology degree. This means you get a solid foundation in biological science knowledge and key skills. It also means you are ready to address the needs of employers.
With the right qualifications you may be able to get advanced entry into the second year of this degree. This would reduce the time and cost of your degree.
The work of our world-leading life sciences researchers shapes what we teach and how we teach it. This means you'll get a good understanding of the fundamentals of the field. It also means that you will learn the latest advances and be well-prepared for life after your degree.
You can apply to work on your final year Honours project in one of our research labs here in Dundee. You'll get experience of working on real-world projects, trying to solve global problems.
We also have a wide range of other Life Sciences degrees to choose from.
Professional accreditation

This degree is accredited by the Royal Society of Biology
Rankings
10th in UK, 2nd in Scotland for Graduate Prospects in Biological Sciences
Complete University Guide 2027
Joint 9th in the UK for Biological Sciences
The Times and The Sunday Times Good University Guide 2026
Contact our enquiry team
If you have any questions about the admissions process, studying, or living in Dundee, please contact us